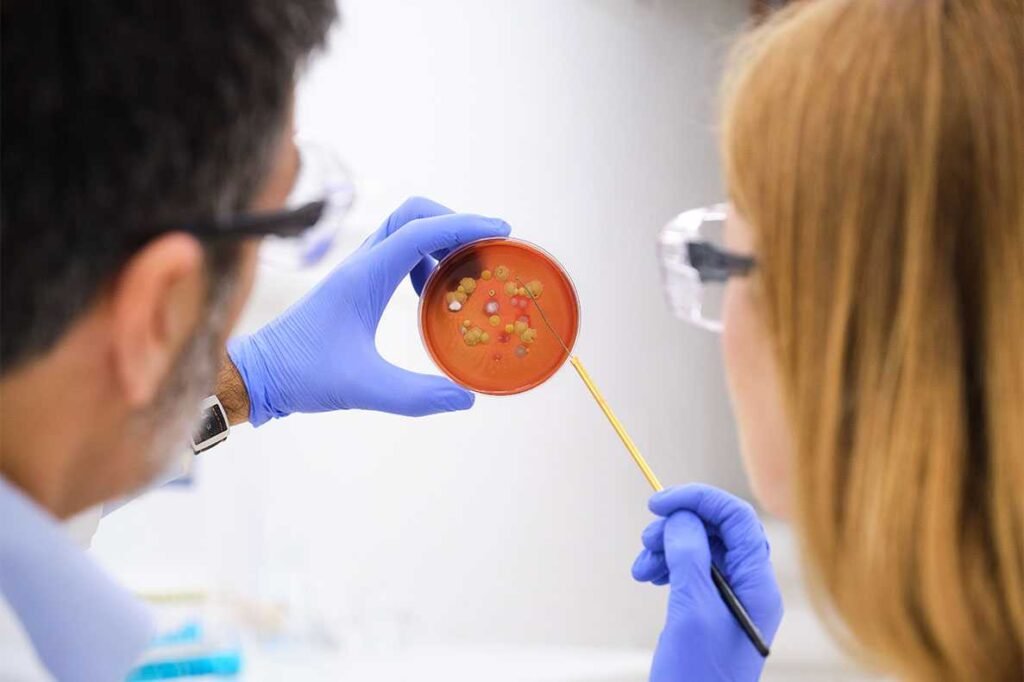

O NADH (Nicotinamida adenina dinucleotídeo + Hidrogénio) é uma coenzima fundamental que desempenha um papel essencial no processo de produção de energia dentro das células. Participando de reações catabólicas, o NADH ajuda a quebrar moléculas e libertar energia, sendo crucial para a respiração celular. Este artigo explora como o NADH contribui para a saúde celular, o seu impacto no envelhecimento, doenças crónicas e outras condições de saúde, além de destacar os benefícios do seu uso como suplemento.
O Papel do NADH na Produção de Energia
Quanto maior a quantidade de NADH disponível nas células, maior será a capacidade destas de desempenharem as suas funções com eficiência. O NADH é uma parte fundamental da maquinaria celular, pois está envolvido no processo de conversão dos alimentos em energia utilizável pelas células. A sua função não se limita a fornecer energia; ele também protege o material genético, mantendo a integridade celular, o que é vital para a saúde a longo prazo.
Protegendo o DNA e Combatendo Agressores Externos
O nosso DNA é protegido no núcleo das células por histonas e outras macromoléculas. No entanto, ele pode ser danificado quando exposto a agentes agressivos, como radiações UV, toxinas químicas, antibióticos, anti-inflamatórios, agrotóxicos, entre outros. A cada ano, novas substâncias químicas são produzidas, muitas das quais podem ser tóxicas para as nossas células e causar lesões ao DNA, alterando a sua estrutura e função.
Quando o DNA é danificado, as células podem replicar esse material genético alterado, levando à ocorrência de mutações. Essas modificações podem resultar em doenças crónicas e degenerativas, como cancro, artrite reumatoide, aterosclerose e doenças autoimunes. Para proteger o DNA e garantir a continuidade da reprodução celular sem alterações genéticas, o corpo humano desenvolveu um sistema de reparação. Este processo de reparação é altamente dependente da presença do NADH, que é necessário para restaurar a integridade do DNA danificado.
Benefícios do NADH: Para a Energia, Saúde Mental e Proteção Contra Doenças
O NADH tem demonstrado benefícios substanciais em várias áreas da saúde, especialmente quando se trata de melhorar a função celular e combater o envelhecimento e as doenças. Aqui estão alguns dos principais benefícios que a suplementação com NADH pode proporcionar:
-
Síndrome de Fadiga Crónica (SFC)
O NADH é eficaz na melhoria da síndrome de fadiga crónica ao restabelecer as reservas de ATP (adenosina trifosfato), que são essenciais para o fornecimento de energia celular. Este restabelecimento ajuda a aliviar os sintomas de fadiga e a disfunção cognitiva, proporcionando mais energia e vitalidade. -
Redução dos Sintomas de Depressão
Estudos sugerem que o NADH pode ajudar a reduzir os sintomas de depressão, como a falta de iniciativa, interesse e concentração. A sua ação estimula a reposição de dopamina, um neurotransmissor relacionado com o prazer, a motivação e o bem-estar emocional. -
Potencialização da Performance Atlética
Para os atletas, o NADH pode ser um aliado importante, uma vez que ajuda a melhorar os níveis energéticos, permitindo um melhor desempenho físico e uma recuperação mais rápida após o exercício. -
Função Antioxidante e Proteção Contra Radicais Livres
O NADH é um poderoso antioxidante, ajudando a proteger as células contra os danos causados pelos radicais livres, que estão associados a várias condições de saúde, como o cancro, doenças cardíacas, diabetes e doenças neurodegenerativas como o Parkinson e o Alzheimer. -
Melhora da Memória e Funções Cognitivas
Em casos de doenças neurodegenerativas, como o Alzheimer e o Parkinson, o NADH tem demonstrado melhorar as funções da memória, a fluência verbal e a perceção visual. Este efeito ocorre devido ao estímulo à produção de dopamina, um neurotransmissor essencial para o funcionamento cognitivo e a coordenação motora. -
Proteção Hepática
O NADH também pode proteger o fígado, especialmente contra os efeitos nocivos do consumo excessivo de álcool, promovendo a regeneração celular e a desintoxicação hepática. -
Diminuição da Tensão Arterial e Colesterol
A suplementação com NADH pode ajudar a reduzir os níveis de colesterol LDL (“mau”) e a tensão arterial, promovendo a saúde cardiovascular e ajudando a prevenir doenças do coração. -
Fortalecimento do Sistema Imunitário
O NADH pode reforçar o sistema imunitário ao melhorar a função dos macrófagos, células responsáveis pela defesa do organismo contra patógenos. Este efeito é particularmente útil em momentos de maior exposição a agentes infecciosos ou durante períodos de maior stress.
A Importância do NADH na Saúde a Longo Prazo
Em suma, o NADH é uma coenzima vital para o nosso organismo, responsável pela produção de energia nas células e pelo transporte de electrões no processo de respiração celular. Além disso, é um dos principais antioxidantes, ajudando a combater os danos causados pelo envelhecimento e pelas toxinas ambientais. A suplementação com NADH pode melhorar significativamente a qualidade de vida, promovendo mais energia, melhor saúde mental e proteção contra várias doenças crónicas e degenerativas.
Curiosidade: Os Primeiros Estudos sobre o NADH
Os primeiros estudos científicos sobre o NADH foram realizados pelo Prof. Georg Birkmeyer, director do Birkmeyer Institute for Parkinson Therapy. O seu trabalho inicial focou-se na aplicação do NADH em casos de Parkinson, Alzheimer e depressão, demonstrando efeitos positivos no tratamento dessas condições. O Prof. Birkmeyer e a sua equipa continuaram a investigar o potencial terapêutico do NADH, resultando em mais de 100 artigos científicos publicados sobre o tema.
O Poder do NADH na Promoção da Saúde
Com os seus múltiplos benefícios, o NADH surge como uma coenzima indispensável para o bom funcionamento celular, a produção de energia e a protecção contra doenças. Seja para melhorar a energia, combater a fadiga crónica ou proteger o cérebro e o sistema cardiovascular, o NADH é uma ferramenta poderosa para manter a saúde e o bem-estar ao longo da vida. Como sempre, a consulta com um profissional de saúde é recomendada antes de iniciar qualquer regime de suplementação, garantindo assim a melhor escolha para as suas necessidades individuais.